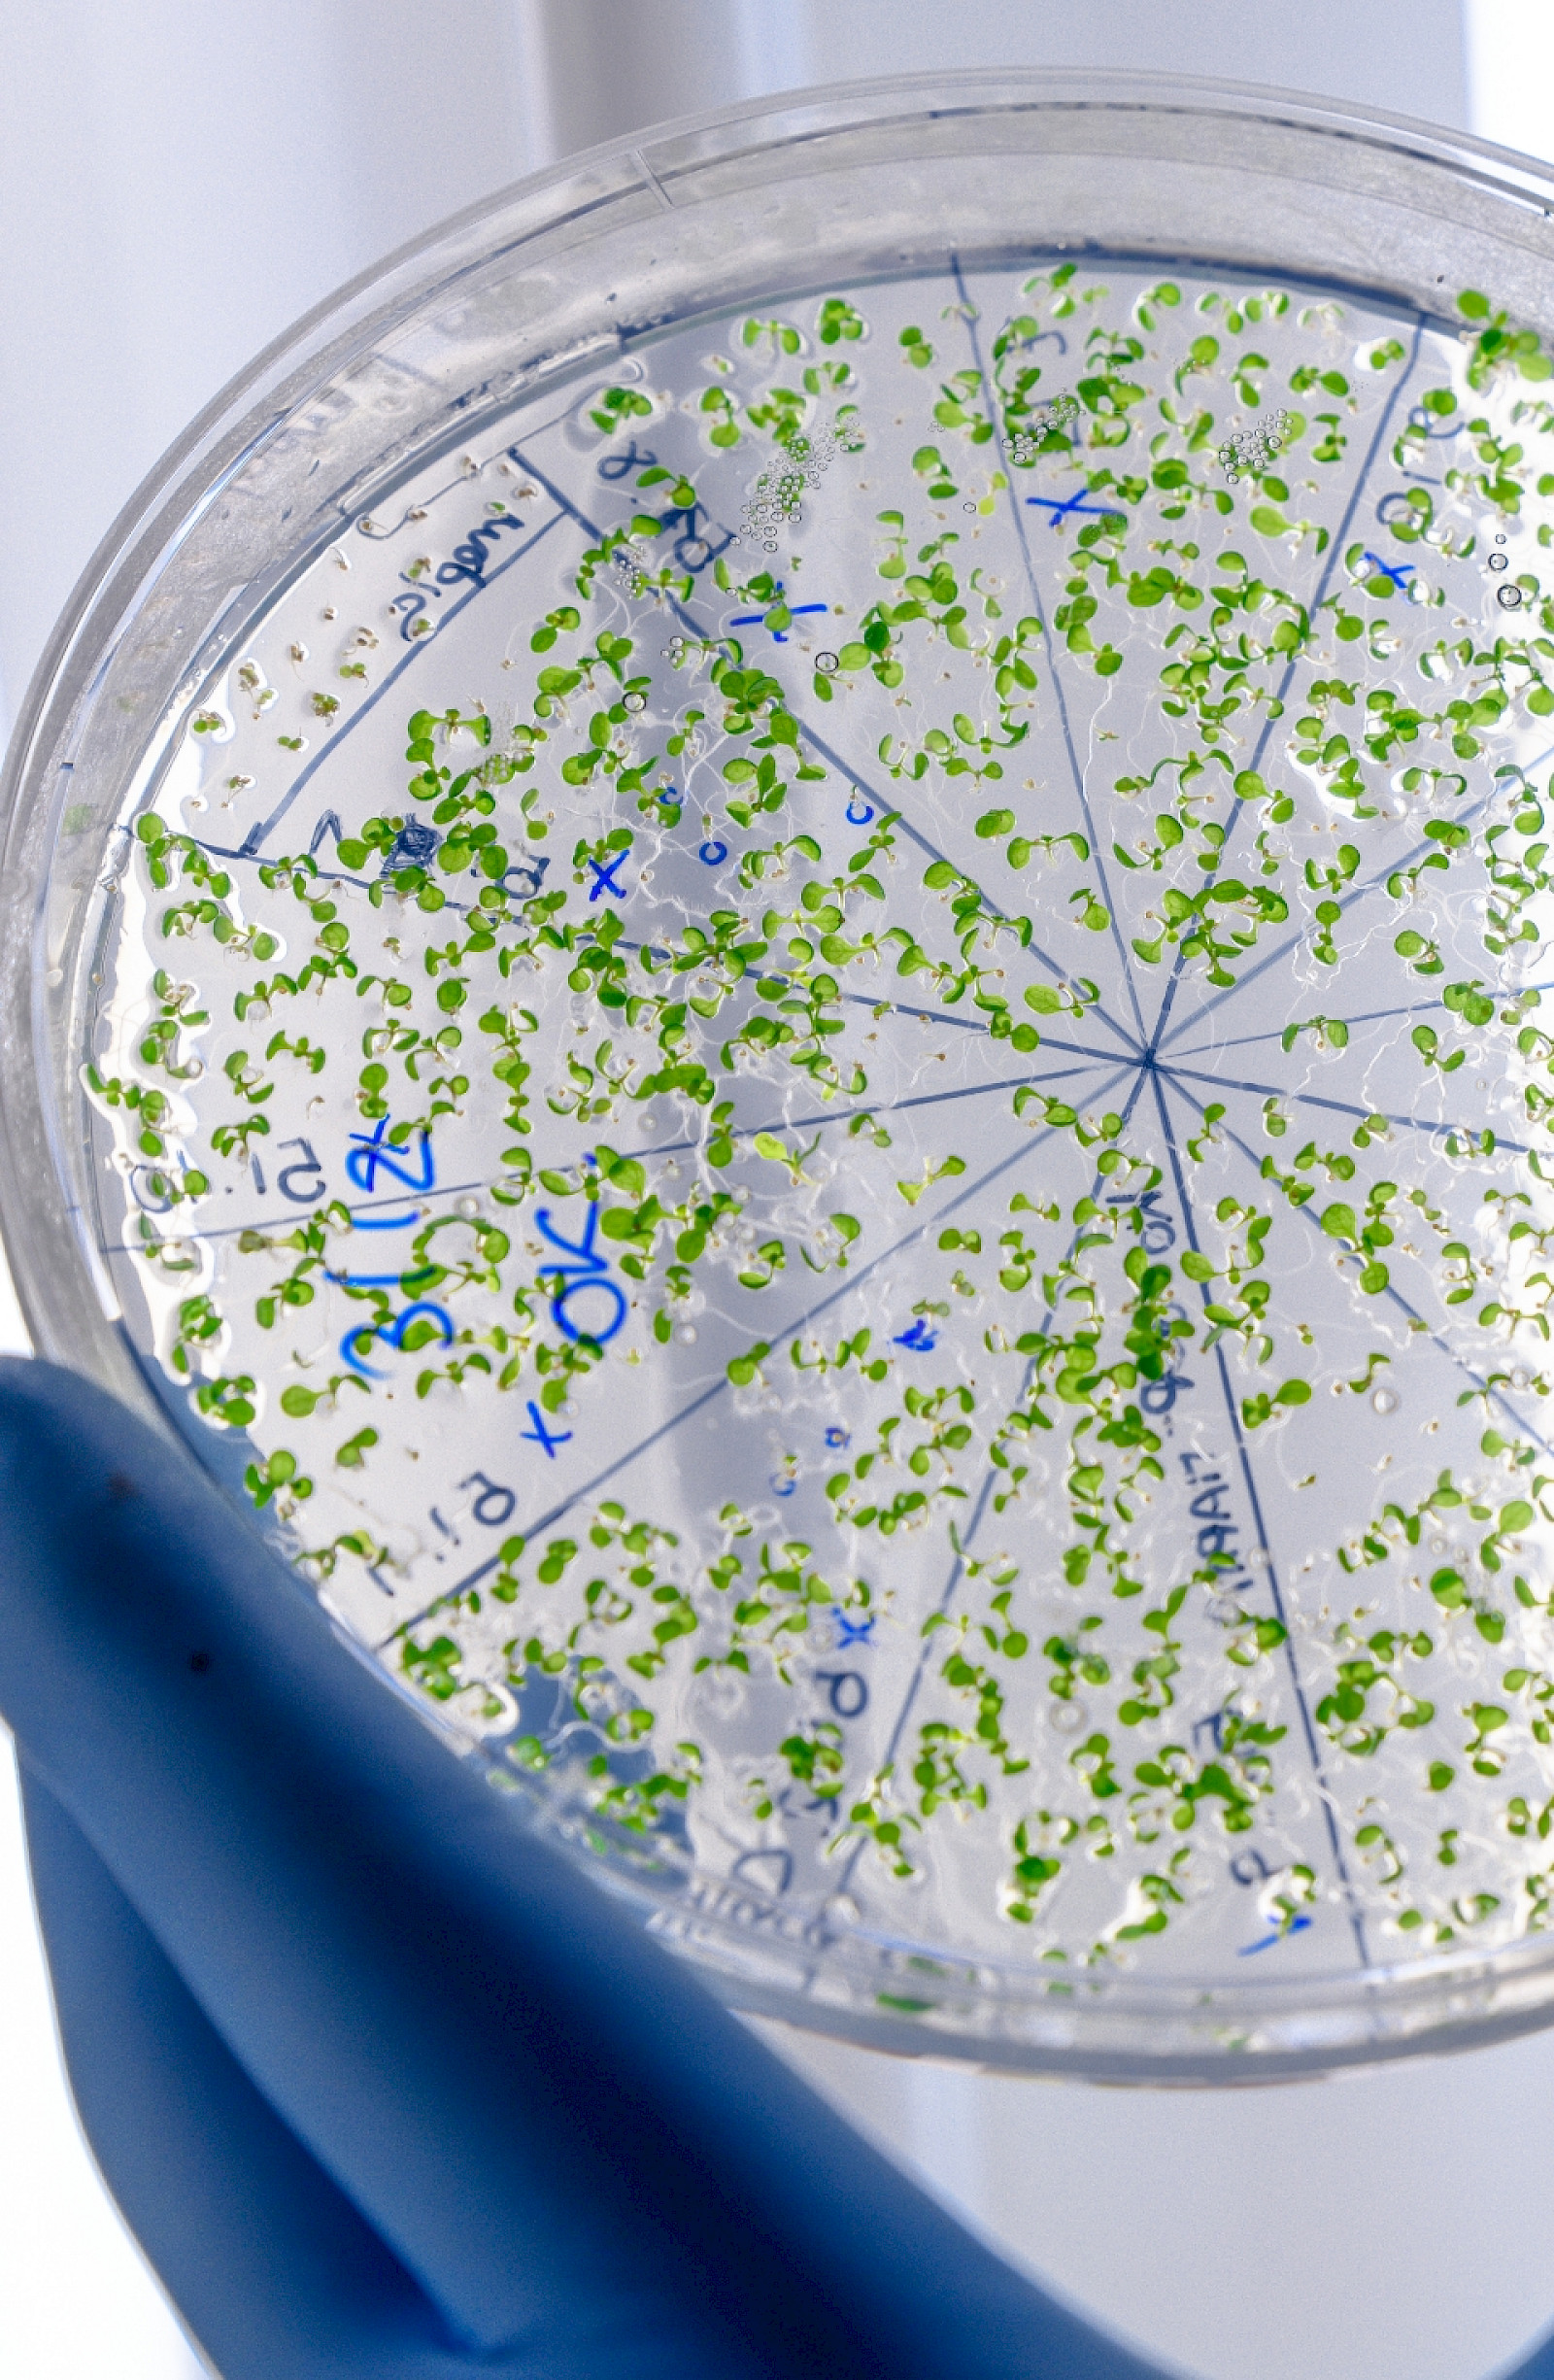

The main contaminants found in water systems are installation debris, scale, corrosion products and biological fouling. These cause various problems but in general, can detrimentally affect the operating efficiency and life of the system materials.
The following services are not directly supplied however as a provider of comprehensive water solutions we are able to act as introducers to suitably accredited and LCA certified companies.
contact us today to find our more about our water treatment solutions
The success of Nemco taking on this contract is quite apparent ... Nemco [were] able to identify annual savings of 40%